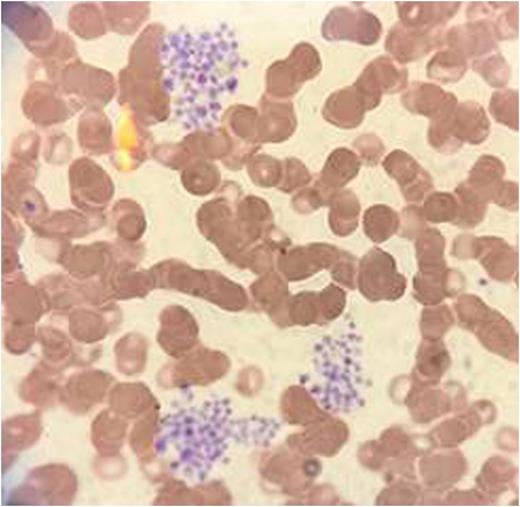
Figure 1. Platelet Clumps- Magnification 60X Oil

Abstract
Introduction:
Pseudo-thrombocytopenia (PTCP) is a benign artifact which generates anxiety in the patients and physicians resulting in unnecessary investigations. We report a case with profound artefactual thrombocytopenia.
Case:
A 31-years-old female in 38th week of gestation was referred to hematology clinic for evaluation of a platelet count of 48x109/L. A month ago platelet count was 102x109/L. She denied any symptoms. Examination was normal with no ecchymosis or petechiae. Laboratory work showed a white cell count of 11.2x109/L, hemoglobin 10.3g/L, platelet count 8x109/L and no hemolysis. Peripheral blood smear showed numerous platelet clumps (Figure 1). Estimated manual platelet count was 200x109/L. To our surprise clumps and low machine count were seen in samples drawn in sodium citrate and heparin tubes as well.
Discussion:
Ethylenediaminetetra-acetic acid (EDTA) dependent PTCP is a rare phenomenon with incidence of 0.09%-0.21% in general population (1). It is present in healthy subjects (2), severely ill patients with sepsis (3), autoimmune, neoplastic and liver diseases (4). PTCP may persist for 15-20 years without any clinical manifestations (5). Platelet aggregation in PTCP is due to anti-platelet antibody mediated in-vitro activation via GPIIb receptors (6). Antibodies may be IgG, IgA or IgM (5). It may be seen in samples drawn in citrate (5) heparin (7) and sodium-oxalate (8). One should suspect PTCP when there is fall in platelet count (usually <100x109/L), time-dependent spurious elevation of white cells(9), a normal mean platelet volume (4) or microscopic detection of platelet aggregates (1) in a patient without clinical manifestations. There is a rare report that addition of amikacin could inhibit and dissociate pseudo platelet aggregation in multianticoagulant-dependent pseudo-thrombocytopenia and EDTA-induced pseudo-thrombocytopenia (10). Early identifications is extremely essential when therapeutic decision making hinges on platelet count viz. management of acute myocardial infarction (11).Use of samples at 37°C (2), ammonium oxalate (5, 7), addition of amikacin and peripheral smear review may help in complicated cases.
References:
1. Yoneyama A, Nakahara K. [EDTA-dependent pseudothrombocytopenia--differentiation from true thrombocytopenia]. Nihon Rinsho. 2003;61(4):569-74.
2. Lippi G, Plebani M. EDTA-dependent pseudothrombocytopenia: further insights and recommendations for prevention of a clinically threatening artifact. Clin Chem Lab Med. 2012;50(8):1281-5.
3. Mori M, Kudo H, Yoshitake S, Ito K, Shinguu C, Noguchi T. Transient EDTA-dependent pseudothrombocytopenia in a patient with sepsis. Intensive Care Med. 2000;26(2):218-20.
4. Berkman N, Michaeli Y, Or R, Eldor A. EDTA-dependent pseudothrombocytopenia: a clinical study of 18 patients and a review of the literature. Am J Hematol. 1991;36(3):195-201.
5. Bizzaro N. EDTA-dependent pseudothrombocytopenia: a clinical and epidemiological study of 112 cases, with 10-year follow-up. Am J Hematol. 1995;50(2):103-9.
6. Fiorin F, Steffan A, Pradella P, Bizzaro N, Potenza R, De Angelis V. IgG platelet antibodies in EDTA-dependent pseudothrombocytopenia bind to platelet membrane glycoprotein IIb. Am J Clin Pathol. 1998;110(2):178-83.
7. Zandecki M, Genevieve F, Gerard J, Godon A. Spurious counts and spurious results on haematology analysers: a review. Part I: platelets. International Journal of Laboratory Hematology. 2007;29(1):4-20.
8. Schrezenmeier H, Muller H, Gunsilius E, Heimpel H, Seifried E. Anticoagulant-induced pseudothrombocytopenia and pseudoleucocytosis. Thromb Haemost. 1995;73(3):506-13.
9. Xiao Y, Xu Y. Concomitant spuriously elevated white blood cell count, a previously underestimated phenomenon in EDTA-dependent pseudothrombocytopenia. Platelets. 2015;26(7):627-31.
10. Zhou X, Wu X, Deng W, Li J, Luo W. Amikacin can be added to blood to reduce the fall in platelet count. Am J Clin Pathol. 2011 Oct;136(4):646-52.
11. Kocum TH, Katircibasi TM, Sezgin AT, Atalay H. An unusual cause of mismanagement in an acute myocardial infarction case: pseudothrombocytopenia. Am J Emerg Med. 2008;26(6):740 e1-2.
No relevant conflicts of interest to declare.
Author notes
Asterisk with author names denotes non-ASH members.

This feature is available to Subscribers Only
Sign In or Create an Account Close Modal